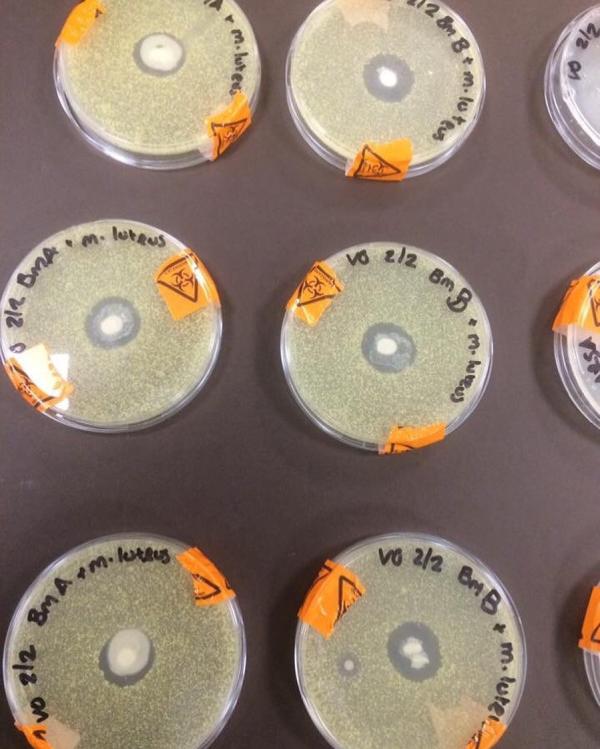
post image

Я бы поубивала их всех.
Ладно я, молодая девушка , которая вкурсе этих разводов.
Но бабушки, дедушки .... сколько уже своровано тысяч, отложенных на «старость/похороны/лекарства/еду» ....
Боже, надеюсь карма настигнет их .
Девочки, привет. У меня очередной свист😄😄😄
Едем в Москву с детьми, насчёт бронирования отеля мы определились! Спасибо всем за советы! Теперь вопрос другой: брать ли с собой коляску? Едем всего на 5 дней. Коляска для путешествий у нас есть. Дочке 1,9. Пешком сама ходит, но вдруг откажется ножками топать, тогда что на себе не таскать?))) Когда ездим отдыхать на моря берём с собой коляску, там понятно потому что на 2 недели как минимум уезжали. Брать или не брать? У кого есть опыт таких поездок по...

Много букв, много мыслей.
Сегодня осознала, насколько моя дочь стала большой. А ведь недавно ей было 2 года, недавно она баловалась, сильно баловалась, кризисы 2х,3х,5х...., мы вместе через это просшли, спасибо свекрови. Что она всегда была рядом, а то я в свои 20 и с полнейшим не знание о детях ничегошеньки, точно бы вздернулась когда-нибудь. Первый декрет был веселый. Мы собственно отрывались, когда дочке было 3 месяца. Без проблем оставалась с бабулей, у них своя тесная связи и по сей день. ...
На фотографии, размещенной студентом-биологом в Англии, изображены девять чашек Петри, полностью колонизированных бактериями M. Luteus, за исключением центра, где крошечные лужи грудного молока создали нечто вроде «рва» защиты вокруг себя ».
Студентка, Вики Грин, сказала, что у нее были аналогичные результаты с чашками Петри, полными e.Coli и страшной антибиотической устойчивостью MRSA «супер жук».
«Белые пятна в середине - это диски, пропитанные двумя образцами грудного молока», ...